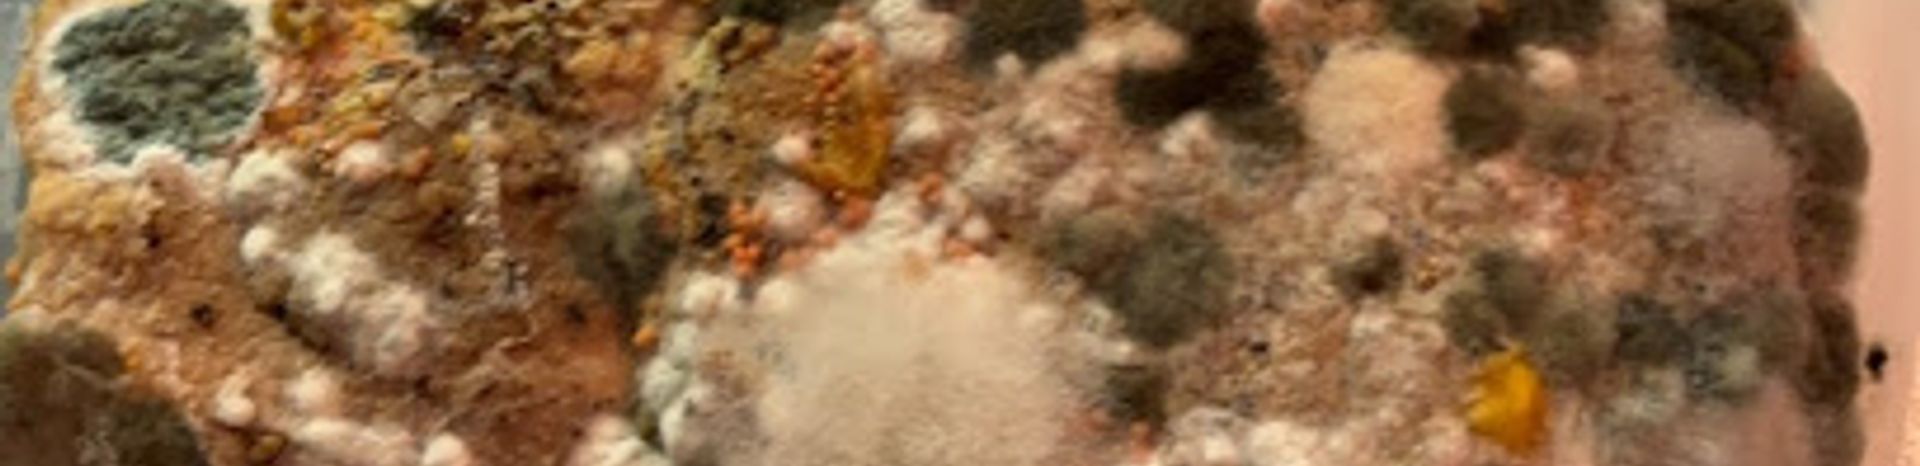
Background

Bazart
Bazart: A Unique Bar Experience in Montreal
Discover the lively charm and innovative cocktails at Le 658, a must-visit bar in the heart of Montreal's nightlife.
Nestled in the heart of Montreal, Le 658 is a trendy bar that captivates visitors with its lively ambiance and creative cocktails. A must-visit for any tourist looking to immerse themselves in the local nightlife.
Opening times, essentials, and a few local tips gathered into one calmer, easier-to-scan planning section.
Use Tower Bridge as your starting point for nearby food, family ideas, nightlife, and more local discoveries.

Explore expert travel guides, compare and book tours, experiences, hotels, and more—all from the palm of your hand. Download now for seamless trip planning wherever your wanderlust takes you.

Discover Montreal: A vibrant city where historic charm meets modern flair, offering a rich cultural tapestry, world-renowned festivals, and a culinary scene that delights.
Tell me more about Montreal